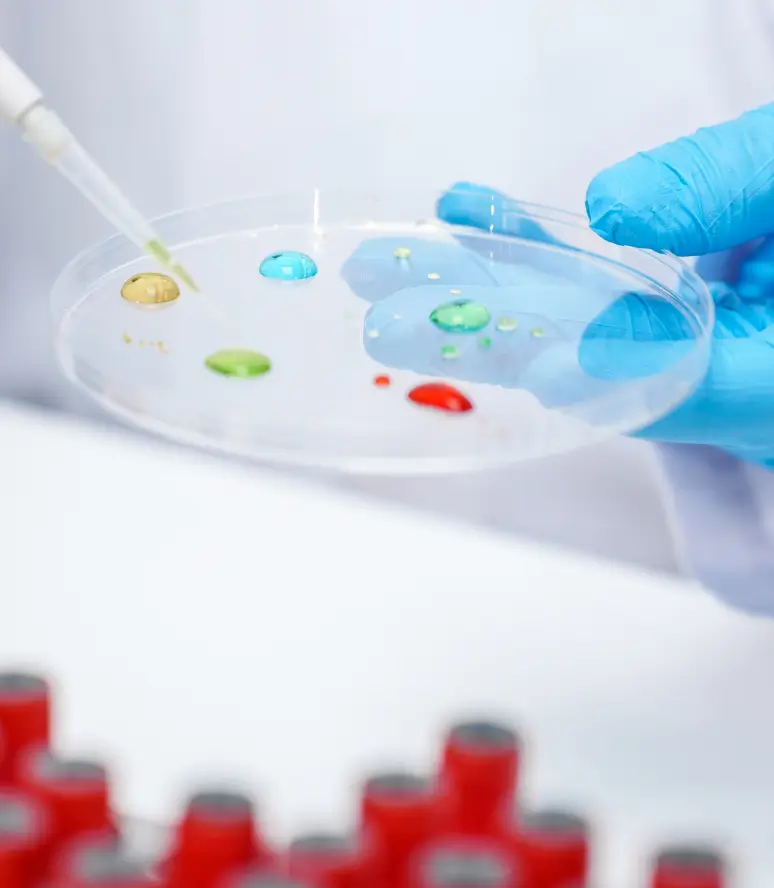

Webinars
Latest Webinars

From Proxy to Precision: Shifting Toward Human-Specific Translational Immune Models
Discover why drug development is shifting from animal models to human-specific immune systems, and how Synexa helps bridge the gap…

Sailing Through Chelation Chaos to Unbound Success
The challenges of analysing metal chelating compounds in bioanalytical studies demand precise expertise and oversight. This case study highlights the…

Bioanalytical Considerations for Successful Clinical Trials
Discover how strategic bioanalytical planning and LC-MS/MS method implementation can streamline clinical trials and safeguard study success.…

Gyrolab® vs Traditional Immunoassays: An Alternative Approach in Bioanalysis
Explores the transformative potential of Gyrolab® technology in modern immunoassay bioanalysis.…
Overcoming Challenges in ELISpot Method Development and Validation to Support Clinical Trials
Exploring the critical aspects of ELISpot assay development and validation for clinical trials.…

Radiopharmaceutical Bioanalysis Solutions
An overview of Synexa's Radiopharmaceutical Bioanalysis offering as well as case studies highlighting the pros and cons of various assay…
Improving the quality of human health
Contact us
Discuss biomarker and bioanalytical solutions to accelerate your therapeutic pipeline
